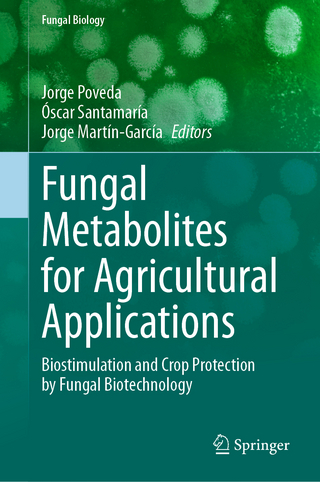
Fungal Metabolites for Agricultural Applications

Baseball's Neglected Trailblazer for Today's Millionaire Athletes
Buch | Hardcover
2025
|
Rowman & Littlefield
ISBN: 9798881804756
CHF 55,90 (inkl. MwSt)
- Titel wird nachgedruckt